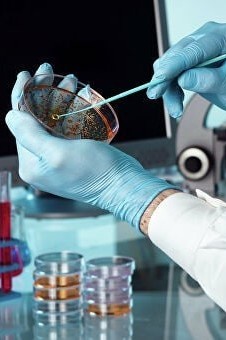

Jahon sogʻliqni saqlash tashkiloti hisobotiga koʻra, bu holat dunyo aholisi salomatligiga tahdid solayotgan 10 ta asosiy xavf omilidan biridir. Joriy yil 18-24-noyabr kunlari sayyoramizda “Butunjahon mikroblarga qarshi kurash haftaligi” deb eʼlon qilinishining boisi shunda.
Aslida xavotirlar asosli. Virus va bakteriyalarning chidamliligi, yaʼni tibbiy preparatlarga “chap berish” xususiyati ortishi bemorlarni davolashni yanada qiyinlashtirmoqda. Oʻz navbatida, kasallikning tarqalishi uchun qulay muhit yuzaga kelyapti.
Tadqiqotchi va ekspertlar xulosasiga koʻra, agar antibiotiklardan foydalanish boʻyicha amaldagi strategiya oʻzgarmasa, 2050-yilga kelib, infeksiyalarning chidamliligi ortishi oqibatida hayotdan koʻz yumadigan bemorlar soni yiliga 10 million nafarga yetishi mumkin.
Hozir bu koʻrsatkich 5 million nafarni tashkil etayotganini hisobga olsak, zamonaviy tibbiyot bu borada tezkor va samarali yechimlarga muhtoj ekanligi yana bir bor oydinlashadi.
Tadqiqotchilarning taʼkidlashicha, koronavirus pandemiyasi davrida turli vahima va xavotirlar ortidan antibakterial preparatlar haddan ziyod koʻp qoʻllanildi. Oqibatda infeksiyalarning dorilarga chidamlilik xususiyati yanada ortishi kuzatildi, deb xabar beradi Sogʻliqni saqlash vazirligi matbuot xizmati.